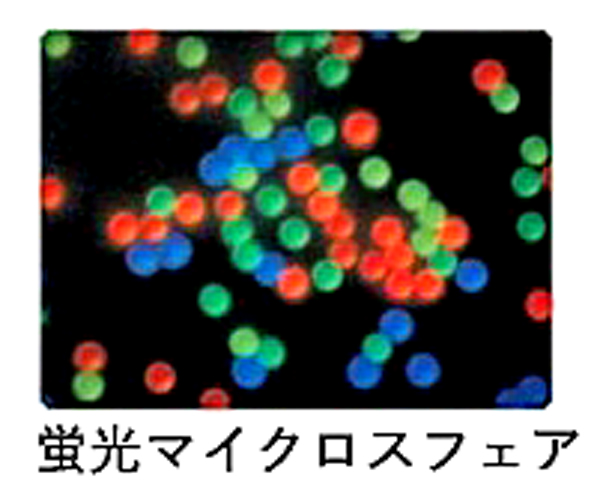

これまで我々は、蛍光マイクロスフェア法を用いて、鍼刺激によるラットの筋循環に及ぼす影響とそのメカニズムについて検討してきました。
筋循環と聞くと簡単に測定できるように思われがちですが、測定法にはそれぞれ長所と短所があり、筋の血流量を正確に測定するのは大変難しいです。まして鍼のような微小な刺激による変化を捉えるには、非侵襲的で感度の良い測定法が必要となります。
マイクロスフェアとは、蛍光物質が塗布された直径15マイクロメートルのプラスチック製の球体のことです。これをラットの頚動脈に挿入したカテーテルから上行大動脈(血中)へ投与し、全身にばらまきます。血中に乗って全身にばらまかれたマイクロスフェアは、細動脈を介し、毛細血管に詰まります。これをトラップ(捕捉)されると言います。運動時など、細動脈が拡張すると毛細血管に多くの血液が流れ込みますので、これに比例して、毛細血管にトラップされるマイクロスフェアの数も増えます。また、その逆もしかりです。
仮に、同じ個体の任意の筋の血流量が分かれば、その筋と対象筋のマイクロスフェア数の比率から、対象筋の血流量を求めることができます。マイクロスフェア法の面白いところは、この任意の筋(疑似筋)を採血で作り上げるところにあります。詳細は省きますが、対象筋の重量と採血の速度、対象筋と採血した血液の蛍光度から、対象筋の血流量を測定することができます。
勘の良い方は、すでにお気付きかと思いますが、この方法では、複数の筋の血流量を同時に測定することができます。また、測定用プローブを筋に静置あるいは挿入する必要もありませんので、非侵襲的に血流量を測定することができます。これは、生体に微小な損傷を与える鍼の研究にとって欠かすことのできないメリットです。
研究の成果は、また別の機会にお話しできればと思います。
筋循環と聞くと簡単に測定できるように思われがちですが、測定法にはそれぞれ長所と短所があり、筋の血流量を正確に測定するのは大変難しいです。まして鍼のような微小な刺激による変化を捉えるには、非侵襲的で感度の良い測定法が必要となります。
マイクロスフェアとは、蛍光物質が塗布された直径15マイクロメートルのプラスチック製の球体のことです。これをラットの頚動脈に挿入したカテーテルから上行大動脈(血中)へ投与し、全身にばらまきます。血中に乗って全身にばらまかれたマイクロスフェアは、細動脈を介し、毛細血管に詰まります。これをトラップ(捕捉)されると言います。運動時など、細動脈が拡張すると毛細血管に多くの血液が流れ込みますので、これに比例して、毛細血管にトラップされるマイクロスフェアの数も増えます。また、その逆もしかりです。
仮に、同じ個体の任意の筋の血流量が分かれば、その筋と対象筋のマイクロスフェア数の比率から、対象筋の血流量を求めることができます。マイクロスフェア法の面白いところは、この任意の筋(疑似筋)を採血で作り上げるところにあります。詳細は省きますが、対象筋の重量と採血の速度、対象筋と採血した血液の蛍光度から、対象筋の血流量を測定することができます。
勘の良い方は、すでにお気付きかと思いますが、この方法では、複数の筋の血流量を同時に測定することができます。また、測定用プローブを筋に静置あるいは挿入する必要もありませんので、非侵襲的に血流量を測定することができます。これは、生体に微小な損傷を与える鍼の研究にとって欠かすことのできないメリットです。
研究の成果は、また別の機会にお話しできればと思います。
関連リンク
-
新原寿志教授についての情報はこちら











